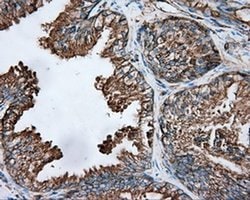
Invitrogen TUBA8 Monoclonal Antibody (OTI2G6) 100 &mu;L; Unconjugated:Antibodies,

Promotional price valid on web orders only. Your contract pricing may differ. Interested in signing up for a dedicated account number?
Learn More
Learn More
Invitrogen™ TUBA8 Monoclonal Antibody (OTI2G6)


Mouse Monoclonal Antibody
Supplier: Invitrogen™ MA525082
Description
TUBA8 Monoclonal Antibody for Western Blot, ICC/IF, IHC (P), IP
This gene encodes a member of the alpha tubulin protein family. Alpha tubulins are one of two core protein families (alpha and beta tubulins) that heterodimerize and assemble to form microtubules. Mutations in this gene are associated with polymicrogyria and optic nerve hypoplasia. Alternate splicing results in multiple transcript variants.
Specifications
| TUBA8 | |
| Monoclonal | |
| 0.82 mg/mL | |
| PBS with 1% BSA, 50% glycerol and 0.02% sodium azide; pH 7.3 | |
| Q6AY56, Q9NY65 | |
| TUBA8 | |
| Full length human recombinant protein of TUBA8 produced in HEK293T cell. | |
| 100 μL | |
| Primary | |
| Human, Rat, Canine, Monkey | |
| Antibody | |
| IgG2a |
| Immunohistochemistry (Paraffin), Immunoprecipitation, Western Blot, Immunocytochemistry | |
| OTI2G6 | |
| Unconjugated | |
| TUBA8 | |
| alpha tubulin 8; alpha-tubulin 8; TUBA8; TUBAL2; tubulin alpha 8; tubulin alpha chain-like 2; Tubulin alpha-8 chain; tubulin, alpha 8 | |
| Mouse | |
| Affinity Chromatography | |
| RUO | |
| 486762, 500377, 51807 | |
| -20°C, Avoid Freeze/Thaw Cycles | |
| Liquid |
Product Content Correction
Your input is important to us. Please complete this form to provide feedback related to the content on this product.
Product Title
Spot an opportunity for improvement?Share a Content Correction